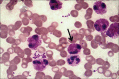

Quantitative analysis of tumor-associated tissue eosinophils and tumor-associated blood eosinophils in oral squamous cell carcinoma
- PMID: 32508461
- PMCID: PMC7269303
- DOI: 10.4103/jomfp.JOMFP_70_18
Quantitative analysis of tumor-associated tissue eosinophils and tumor-associated blood eosinophils in oral squamous cell carcinoma
Abstract
Background: Stromal response to cancer is usually characterized by intense lymphoplasmacytic infiltrate. However, recently, the attention has shifted to tumor-associated tissue eosinophils (TATE). Tumor-associated blood eosinophils (TABE) are rare in solid cancers; however, carcinoma of the head and neck shows its prevalence.
Aim: The aim of the study was to investigate the prevalence and relationship of tissue and blood eosinophils in various grades of oral cancer. The purpose of the article is to emphasize the possible clinical and biological significance of eosinophils in patients of oral squamous cell carcinoma (OSCC) so that appropriate therapeutic strategies can be devised accordingly.
Study design: Thirty histologically confirmed cases of oral squamous cell carcinoma were divided into well, moderate and poorly differentiated carcinoma. Eosinophilic infiltration in the tissue was graded as low, moderate and massive TATE. The number of eosinophils per 100 WBCs was taken as the differential eosinophil count. Blood eosinophilia (BE) >6% was considered to be TABE.
Materials and methods: Hematoxylin and eosin-stained tissue sections at 5 μ were evaluated. Prolonged staining in dilute 0.05% aqueous eosin demonstrated eosinophils selectively. Blood smears were stained by Leishman stain.
Statistical analysis: Student's t-test, Chi-square test, ANOVA, Newman-Keuls Multiple Comparison Test and Karl Pearson correlation coefficient® method were used.
Results: The mean TATE value was highest in poorly differentiated carcinoma. TABE was seen only in a few cases and was associated mostly with poorly differentiated OSCC.
Conclusion: There was a statistically significant correlation between TATE and histological grades of OSCC. Eosinophilia of the peripheral blood is an adverse sign in patients with carcinoma.
Keywords: Eosinophils; oral cancer; oral squamous cell carcinoma; tumor-associated blood eosinophilia; tumor-associated tissue eosinophilia.
Copyright: © 2020 Journal of Oral and Maxillofacial Pathology.
Conflict of interest statement
There are no conflicts of interest.
Figures

References
-
- Bhargava A, Saigal S, Chalishazar M. Histopathological grading systems in oral squamous cell carcinoma: A review. J Int Oral Health. 2010;2:1–10.
-
- Debta P, Debta FM, Chaudhary M, Wadhwan V. Evaluation of prognostic significance of immunological cells (tissue eosinophil and mast Cell) infiltration in oral squamous cell carcinoma. J Cancer Sci Ther. 2011;3(Suppl 8):201–4.
-
- Hanahan D, Weinberg RA. Hallmarks of cancer: The next generation. Cell. 2011;144:646–74. - PubMed
-
- Lorusso G, Ruegg C. The tumor microenvironment and its contribution to tumor evolution towards metastasis. Histochem Cell Biol. 2008;130(Suppl 6):1091–103. - PubMed
LinkOut - more resources
Full Text Sources
Research Materials